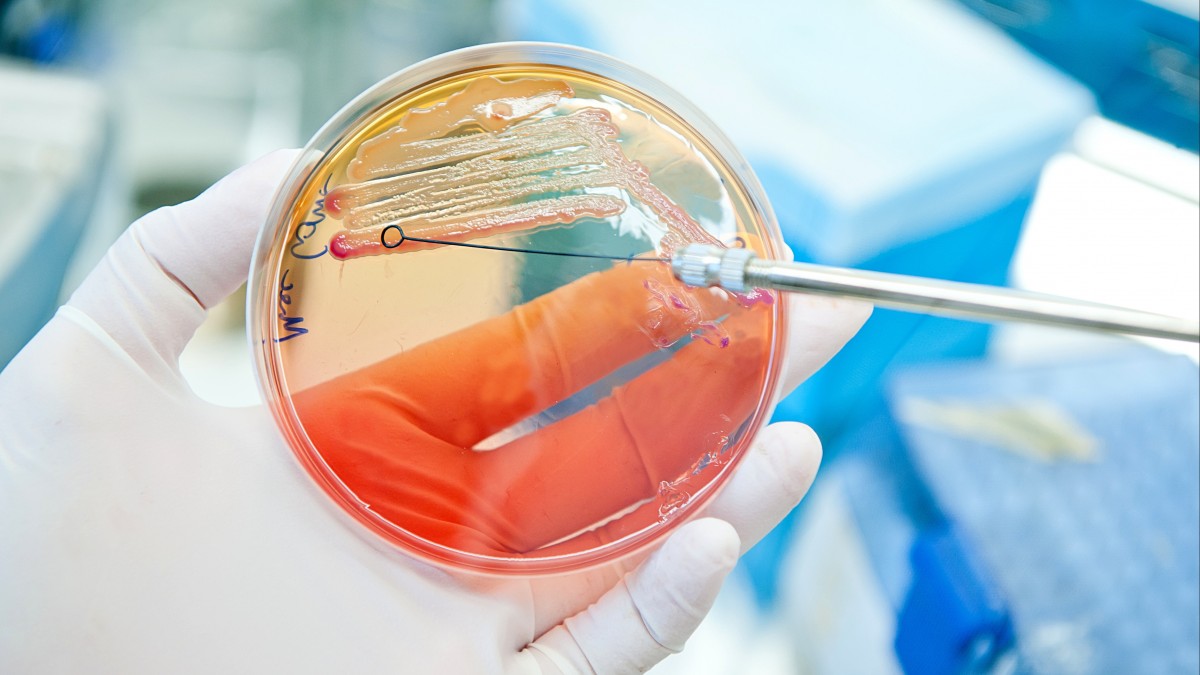
Nowe ognisko E. coli: źródło zakażenia na razie nieznane

Nowe ognisko E. coli: źródło zakażenia na razie nieznane
FHI podaje, że trwa ustalanie źródła zakażenia /zdj. poglądowe stock.adobe.com/standardowa

Ze wstępnych analiz wynika, że u wszystkich zakażonych wykryto bakterię EHEC O26:H11Źródło: stock.adobe.com/standardowa
Nieznane źródło zakażenia

Raport Norwegia
Twoje centrum aktualności i najnowszych wiadomości z Norwegii. Publikujemy dziesiątki informacji dziennie, abyś był zawsze na bieżąco. W jednym miejscu znajdziesz kluczowe informacje: od alertów pogodowych i sytuacji na drogach, przez doniesienia z rynku pracy, po najważniejsze wydarzenia z Oslo, Bergen, Stavanger i wszystkich regionów Norwegii.